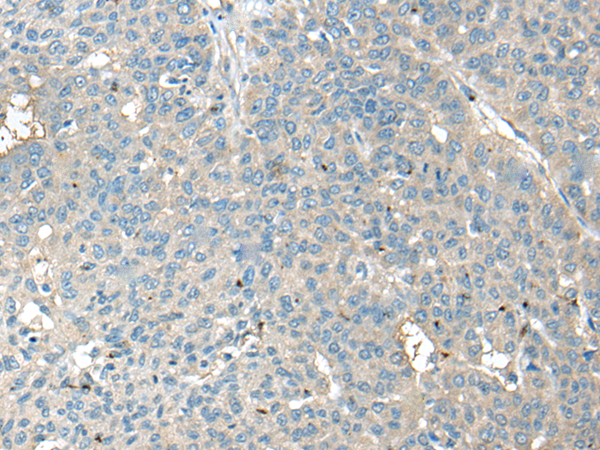
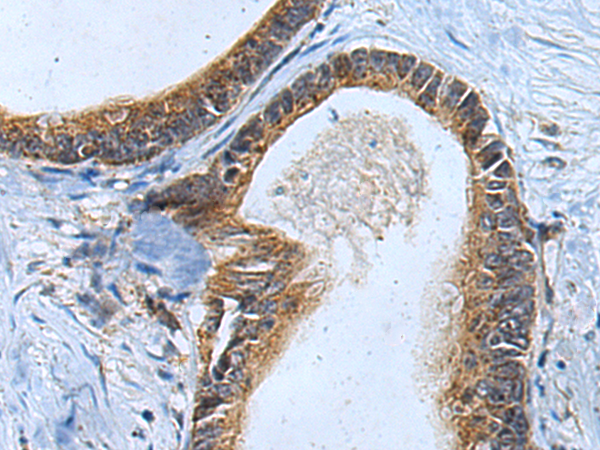
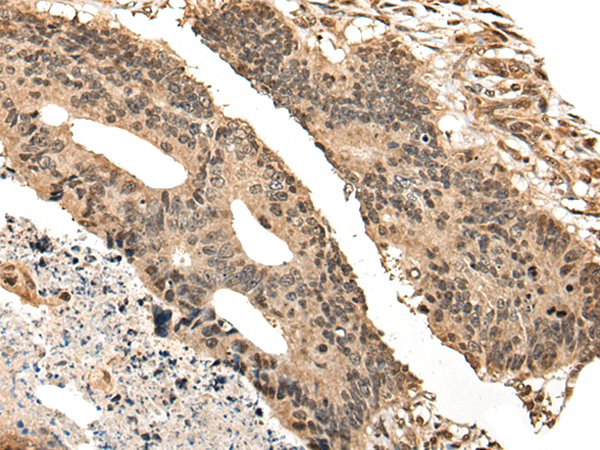

-
分类: 科研抗体货号: P09460别名: CDD应用: WB,IHC反应种属: Human, Mouse
-
分类: 科研抗体货号: P09435别名: CMG; FGS4; LIN2; TNRC8; CAGH39; CAMGUK; MICPCH; MRXSNA应用: WB,IHC反应种属: Human, Mouse, Rat
-
分类: 科研抗体货号: P09451别名: Cctz2; CCTZ-2; TSA303; CCT-zeta-2; TCP-1-zeta-2应用: WB,IHC反应种属: Human, Mouse
-
分类: 科研抗体货号: P09458别名: MIC2; HBA71; MIC2X; MIC2Y; MSK5X应用: WB,IHC反应种属: Human
-
分类: 科研抗体货号: P09434别名:应用: WB反应种属: Human, Mouse
-
分类: 科研抗体货号: P09449别名: HEI10; C14orf18应用: WB,IHC反应种属: Human, Mouse
-
分类: 科研抗体货号: P09457别名: BL11; HB15应用: IHC反应种属: Human
-
分类: 科研抗体货号: P09433别名: CPH应用: WB,IHC反应种属: Human, Mouse, Rat
-
分类: 科研抗体货号: P09447别名: JM11应用: IHC反应种属: Human, Mouse
-
分类: 科研抗体货号: P09456别名: B70; B7-2; B7.2; LAB72; CD28LG2应用: WB,IHC反应种属: Human

鄂公网安备42018502007531号
鄂公网安备42018502007531号

